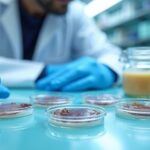
스테비아, 단맛 넘어 암세포까지 겨눈다

인돌 화합물 개발에 새 전기…일본 연구진, 특정 위치 선택적 합성 성공
인돌 구조 화합물의 개발은 의약품 합성의 핵심 기술로 여겨집니다. 최근 일본 연구진이 인돌의 특정 위치(C5)에 선택적으로 작용기를 도입하는 새로운 기술을 개발해 주목받고 있습니다.
인돌, 생물학적 활성을 지닌 핵심 구조
인돌은 벤젠 고리와 질소가 포함된 오각 고리가 융합된 구조로, 자연계와 인체에서 다양한 생물학적 기능을 수행하는 분자입니다.
식물과 균류, 인간의 체내에서도 자연적으로 생성되며, 이 구조를 기반으로 한 유도체는 여러 약물의 핵심 골격으로 사용됩니다.
C5 위치 선택적 수식, 오랜 난제로
인돌 내부의 특정 탄소 위치—특히 C5 위치—를 목표로 작용기를 도입하는 것은 화학적으로 매우 까다롭습니다.
이 위치는 반응성이 낮아 기존에도 접근이 어려웠으며, 새로운 형태의 약물 합성을 제한하는 요소로 작용해 왔습니다.
구리-은 촉매 시스템으로 반응 효율 대폭 향상
치바대학교 연구진은 은과 결합된 구리 기반 촉매를 활용해 인돌의 C5 위치에 알킬기를 선택적으로 도입하는 기술을 개발했습니다.
이 반응에서는 α-디아조말로네이트 유도체에서 생성된 활성 카벤이 주요 전이중간체로 작용하며, 최대 91%의 수율을 달성했습니다.
고도화된 최적화 공정
초기에는 일부 화합물에서 낮은 수율을 보였지만, 촉매 조성, 용매 조건, 출발 물질을 세밀하게 조정함으로써 반응 조건을 최적화했습니다.
이에 따라 다양한 구조의 인돌에 대해 높은 효율의 작용기 도입이 가능해졌습니다.
양자화학 계산으로 반응 경로 확인
양자화학 계산 결과, 초기 카벤은 먼저 인돌의 C4 위치에서 결합한 뒤, 분자 내 재배열을 통해 최종적으로 C5에 결합하는 것으로 나타났습니다.
이때 구리 촉매가 불안정한 중간체를 안정화시키고, 재배열에 필요한 에너지 장벽을 낮추는 핵심 역할을 했습니다.
의약품 개발을 위한 새로운 도구로 주목
이번 기술은 다양한 인돌 유도체에 적용 가능하며, 생체활성을 지닌 분자의 디자인을 위한 강력한 수단으로 활용될 전망입니다.
연구팀은 향후 금속-카벤 화학을 더 발전시켜 인돌 기반 신약 후보 물질의 합성 전략을 지속적으로 확장할 계획입니다.
핵심 요약
- 인돌의 C5 위치에 직접 작용기를 선택적으로 도입하는 기술이 개발됐습니다.
- 구리-은 촉매와 α-디아조말로네이트 유도체를 이용해 최대 91% 수율로 합성에 성공했습니다.
- 양자 계산을 통해 반응 경로와 촉매의 역할을 규명했으며, 향후 약물 개발에 실용화 가능성이 큽니다.
출처 : 원문 보러가기